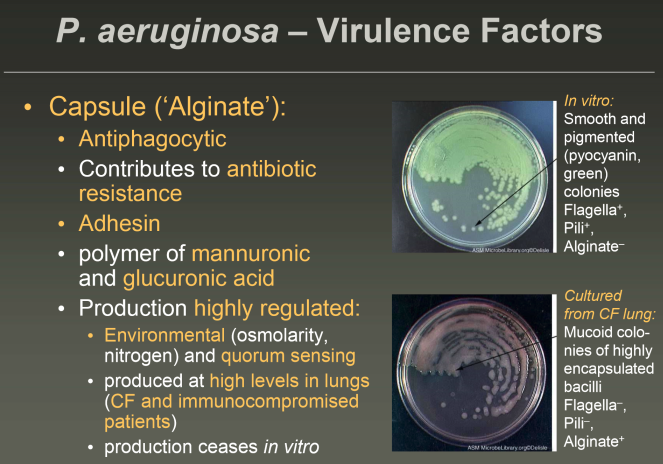

Describe the capsule of Pseudomonas.
Describe the different roles of the exotoxins in Pseudomonas.
(Exotoxin A, S, and U)

Describe the role of Pseudomonas in CF patients.

What patient population is most at risk for pseudomonas pneumonia?

Describe the laboratory diagnosis of Pseudomonas.

What is the role of pyocyanin?
It can cause intracellular oxidative stress leading to lower ATP levels in cells
Describe the characteristics of the two Burkholderia diseases and treatment.

Describe the characteristics of Acinetobacter species.

Acinetobacter is what type of infection?
Nosocomial!

How will acinetobacter grow on blood agar?
Non hemolytic (gamma)
What are the characteristics of Moraxella?

How would you make a laboratory diagnosis of Moraxella?



